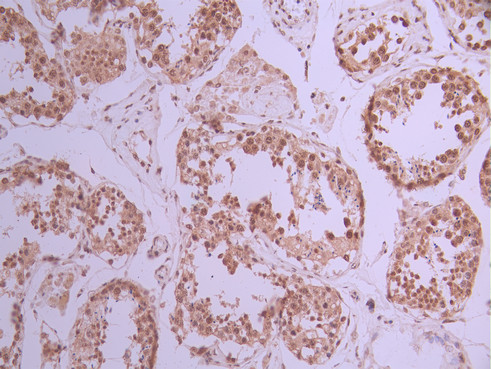

SRSF3 Recombinant Monoclonal Antibody
-
中文名稱(chēng):SRSF3 Recombinant Monoclonal Antibody
-
貨號(hào):CSB-RA932304A0HU
-
規(guī)格:¥1320
-
圖片:
-
Western Blot
Positive WB detected in: HT-29 whole cell lysate(30μg), Hela whole cell lysate(30μg), K562 whole cell lysate(30μg), NIH/3T3 whole cell lysate(30μg)
All lanes: SRSF3 antibody at 1:1000
Secondary
Goat polyclonal to rabbit IgG at 1/40000 dilution
Predicted band size: 19 kDa
Observed band size: 19 kDa
Exposure time:2min -
IHC image of CSB-RA932304A0HU diluted at 1:100 and staining in paraffin-embedded human lung cancer performed on a Leica BondTM system. After dewaxing and hydration, antigen retrieval was mediated by high pressure in a citrate buffer (pH 6.0). Section was blocked with 10% normal goat serum 30min at RT. Then primary antibody (1% BSA) was incubated at 4°C overnight. The primary is detected by a Goat anti-rabbit polymer IgG labeled by HRP and visualized using 0.05% DAB.
-
IHC image of CSB-RA932304A0HU diluted at 1:100 and staining in paraffin-embedded human testis tissue performed on a Leica BondTM system. After dewaxing and hydration, antigen retrieval was mediated by high pressure in a citrate buffer (pH 6.0). Section was blocked with 10% normal goat serum 30min at RT. Then primary antibody (1% BSA) was incubated at 4°C overnight. The primary is detected by a Goat anti-rabbit polymer IgG labeled by HRP and visualized using 0.05% DAB.
-
Immunofluorescence staining of A431 cell with CSB-RA932304A0HU at 1:50, counter-stained with DAPI. The cells were fixed in 4% formaldehyde, permeabilized using 0.2% Triton X-100 and blocked in 10% normal Goat Serum. The cells were then incubated with the antibody overnight at 4°C. The secondary antibody was Alexa Fluor 488-congugated AffiniPure Goat Anti-Rabbit IgG(H+L).
-
Overlay Peak curve showing jurkat cells stained with CSB-RA932304A0HU (red line) at 1:100. The cells were fixed in 4% formaldehyde and permeated by 0.2% TritonX-100 for 10min. Then 10% normal goat serum to block non-specific protein-protein interactions followed by the antibody (1ug/1*106cells) for 45min at 4℃. The secondary antibody used was FITC-conjugated goat anti-rabbit IgG (H+L) at 1/200 dilution for 35min at 4℃.Control antibody (green line) was Rabbit IgG (1ug/1*106cells) used under the same conditions. Acquisition of >10,000 events was performed.
-
-
其他:
產(chǎn)品詳情
-
Uniprot No.:
-
基因名:SRSF3
-
別名:Serine/arginine-rich splicing factor 3 (Pre-mRNA-splicing factor SRP20) (Splicing factor, arginine/serine-rich 3), SRSF3, SFRS3 SRP20
-
反應(yīng)種屬:Human, Mouse
-
免疫原:A synthesized peptide from human SRSF3 protein
-
免疫原種屬:Homo sapiens (Human)
-
標(biāo)記方式:Non-conjugated
-
克隆類(lèi)型:Monoclonal
-
抗體亞型:Rabbit IgG
-
純化方式:Affinity-chromatography
-
克隆號(hào):1C11
-
濃度:It differs from different batches. Please contact us to confirm it.
-
保存緩沖液:Preservative: 0.03% Proclin 300
Constituents: 50% Glycerol, 0.01M PBS, PH 7.4 -
產(chǎn)品提供形式:Liquid
-
應(yīng)用范圍:ELISA, WB, IHC, IF, FC
-
推薦稀釋比:
Application Recommended Dilution WB 1:500-1:2000 IHC 1:50-1:200 IF 1:50-1:200 FC 1:50-1:200 -
Protocols:
-
儲(chǔ)存條件:Upon receipt, store at -20°C or -80°C. Avoid repeated freeze.
-
貨期:Basically, we can dispatch the products out in 1-3 working days after receiving your orders. Delivery time maybe differs from different purchasing way or location, please kindly consult your local distributors for specific delivery time.
-
用途:For Research Use Only. Not for use in diagnostic or therapeutic procedures.
相關(guān)產(chǎn)品
靶點(diǎn)詳情
-
功能:Splicing factor that specifically promotes exon-inclusion during alternative splicing. Interaction with YTHDC1, a RNA-binding protein that recognizes and binds N6-methyladenosine (m6A)-containing RNAs, promotes recruitment of SRSF3 to its mRNA-binding elements adjacent to m6A sites, leading to exon-inclusion during alternative splicing. Also functions as export adapter involved in mRNA nuclear export. Binds mRNA which is thought to be transferred to the NXF1-NXT1 heterodimer for export (TAP/NXF1 pathway); enhances NXF1-NXT1 RNA-binding activity. Involved in nuclear export of m6A-containing mRNAs via interaction with YTHDC1: interaction with YTHDC1 facilitates m6A-containing mRNA-binding to both SRSF3 and NXF1, promoting mRNA nuclear export. RNA-binding is semi-sequence specific.
-
基因功能參考文獻(xiàn):
- Results show that SRSF3 impairs the autoregulation mechanism of SRSF5 and promotes the overexpression of SRSF5 in oral squamous cell carcinoma. PMID: 29857020
- TDP43 alters most splicing events with splicing factor SRSF3 in triple-negative breast cancer. PMID: 29581274
- Loss of SRSF3 expression was significantly associated with poor survival and shorter disease-free survival, particularly in early stages, in colorectal cancer. PMID: 29131639
- Findings reveal the molecular mechanism of SRSF3 in pri-miRNA processing and support the previously proposed explanation for the highly conserved position of CNNC in SRSF3-enhanced pri-miRNA processing. PMID: 29615481
- High expression of SRSF3 is associated with oral squamous cell carcinoma. PMID: 27808105
- MicroRNA-1908-5p contributes to the oncogenic function of the splicing factor SRSF3 via NKIRAS2 axis in osteosarcoma cells. PMID: 28039456
- Dehydroepiandrosterone (DHEA) and cortisol modulate SRSF9 and SRSF3 in a different way and data suggest that the anti-glucocorticoid effect of DHEA, among other mechanisms, is also exerted by modulating the expression of proteins involved in the splicing of the GR pre-mRNA. PMID: 28373129
- that SRSF3 controls the expression of the miR-132/212 cluster through regulating REST expression PMID: 28624413
- Alternative splicing of U2AF1 reveals a shared repression mechanism for duplicated exons controlled by SRF3. PMID: 27566151
- Introduction of point mutations in the SRSF3-binding site or knockdown of SRSF3 expression in cells reduces human papillomavirus 18 929;3434 splicing and E1;E4 production but activates other, minor 929;3465 and 929;3506 splicing. Knockdown of SRSF3 expression also enhances the expression of E2 and L1 mRNAs. PMID: 27489271
- data indicate that the Human Papillomavirus E2 protein links the viral replication cycle to epithelial differentiation via SRSF3, a key cellular regulator of high-risk (HR)-HPV gene expression PMID: 26962216
- Results suggested that SRSF3 is associated with the initiation and development of OSCC and may be a biomarker and therapeutic target of OSCC. PMID: 27429590
- we also demonstrated frequent co-overexpression and positive correlation of DARPP-32, SRp20 and CD44E expression levels in human gastric primary tumors. PMID: 26119931
- Results show that YTHDC1 promotes exon inclusion in targeted mRNAs through recruiting pre-mRNA splicing factor SRSF3 while blocking SRSF10 mRNA binding. PMID: 26876937
- These data indicate that SRSF3 affects a global change of gene expression to maintain cell homeostasis. PMID: 26704980
- We propose that SRSF3 could act as a coordinator of the expression of PDCD4 protein via two mechanisms on two alternatively spliced mRNA isoforms. PMID: 26773498
- This new function of SRSF3 not only explains why overexpression of SRSF3 is required for ovarian cancer cell growth and survival but also offers a new insight into the mechanism of the neoplastic transformation. PMID: 26282282
- SRSF3 and hnRNP H1 are the first splicing factors identified which regulate the production of these functionally distinct HER2 splice variants and therefore maybe important for the regulation of HER2 signaling. PMID: 26367347
- expression either decreased or the protein mislocalized in hepatocellular carcinoma PMID: 25132062
- Results identified modulation of SRSF3 activity as the molecular mechanism by which ORF57 promotes RNA splicing. PMID: 25234929
- Data suggest that the oncogenic potential of SRSF3 might be realized, in part, through the translational repression of PDCD4 mRNA. PMID: 24292556
- Stress-inducible truncated SRSF3 may participate in the acceleration of cell growth through facilitating c-Jun-mediated G1 progression under stressful conditions. PMID: 24190040
- This is the first study that demonstrates that rs1122608 confers protection against ischemic stroke and implicates splicing factor SFSR3 in the disease process PMID: 24190014
- findings disclose an important role of SRSF3 in the regulation of the G1-to-S-phase progression and alternative splicing of HIPK2 in tumor growth PMID: 23503458
- truncated SRSF3 protein may function as a positive regulator of oxidative stress-initiated inflammatory responses in colon cancer cells. PMID: 24284797
- Therefore we conclude that SRSF3 promotes exon 9 skipping of caspase-2 pre-mRNA by interacting with exon 8 PMID: 24321384
- Work described here examined the punctate pattern of SRp20 localization in the cytoplasm of poliovirus-infected cells, demonstrating the partial co-localization of SRp20 with the stress granule marker protein TIA-1. PMID: 23830997
- Digoxin-mediated repression of SRSF3 expression plays a role in the digoxin-mediated inclusion of exon 20 in the IKBKAP transcript generated from the familial dysautonomia mutant allele. PMID: 23711097
- downregulation of SRSF3 represents an endogenous mechanism for cellular senescence that directly regulates the TP53 alternative splicing to generate p53beta PMID: 22777358
- results further define the mechanism of SRp20 cellular redistribution during picornavirus infections PMID: 23255796
- Serine arginine splicing factor 3 is involved in enhanced splicing of glucose-6-phosphate dehydrogenase RNA in response to nutrients and hormones in liver PMID: 23233666
- This study does not confirm a role for genetic variants in the SFRS3 and FKBP4 genes in the pathogenesis of corticosteroid-induced ocular hypertension. PMID: 22921020
- This study found that significant changes in serine/arginine protein 20 (Srp20) gene expression in AD cases and confirmed this using a second cohort of control/AD. PMID: 22788679
- Protein extracts of colon cancer CD133+ cell stem cells were compared to protein extracts of colon cancer cell CD133- stem cells by 2D DIGE. Demonstrated a direct cause-effect relationship between Wnt pathway activation & increased SRp20 expression. PMID: 22623141
- Relative levels of SRp20, SRp30c, and SRp40 in TM cells control differential expression of the two alternatively spliced isoforms of the GR and thereby regulate GC responsiveness. PMID: 22205602
- a model in which SRp20 interacts with PCBP2 bound to the viral RNA, and this interaction functions to recruit ribosomes to the viral RNA in a direct or indirect manner, with the participation of additional protein-protein or protein-RNA interactions. PMID: 21779168
- Silencing of SFRS3 increased IL-1beta secretion due to elevation of IL-1beta and caspase-1 mRNA in addition to active caspase-1 levels. PMID: 21611201
- expression of PTB and SRp20 is associated with malignancy of ovarian tumors but not with stage of invasive epithelial ovarian cancer PMID: 20856201
- Results suggest that increased SRp20 expression in tumor cells is a critical step for tumor initiation, progression, and maintenance. PMID: 21179588
- Epstein-Barr Virus SM protein utilizes cellular splicing factor SRp20 to mediate alternative splicing. PMID: 20810723
- The authors report that siRNA knockdown of SRp20 or 9G8 resulted in about a 10 fold decrease in herpes simplex virus 1 yields and in nuclear accumulation of polyA+ RNA. PMID: 20227104
- insulin induces the proteasome-dependent degradation of SRp20 as well as the subnuclear relocalization of CLIC1 PMID: 15827065
- These results suggest that the C-terminal domain of RPB1 promotes exon skipping by recruiting SRp20 and that this contributes independently of elongation to the transcriptional control of alternative splicing. PMID: 17028590
- nucleo-cytoplasmic SR protein, SRp20, functions in internal ribosome entry site (IRES)-mediated translation of a viral RNA. PMID: 17183366
- abundant SRp20 in cancer cells or undifferentiated keratinocytes is important for the expression of the viral early E6 and E7 by promoting the expression of cellular transcription factor SP1 for transactivation of viral early promoters. PMID: 18945760
- Study reports the splicing factor SRp20 as a novel target gene of beta-catenin/TCF4 signaling. PMID: 18952824
- SRp20, SF2/ASF, and CUG-BP1 act antagonistically to regulate IR alternative splicing in vivo and that the relative ratios of SRp20 and SF2/ASF to CUG-BP1 in different cells determine the degree of exon inclusion. PMID: 19047369
- SRp20 associate with interphase chromatin, and is released from hyperphosphorylated mitotic chromosomes PMID: 19250906
顯示更多
收起更多
-
亞細(xì)胞定位:Nucleus. Nucleus speckle. Cytoplasm.
-
蛋白家族:Splicing factor SR family
-
數(shù)據(jù)庫(kù)鏈接:
Most popular with customers
-
-
YWHAB Recombinant Monoclonal Antibody
Applications: ELISA, WB, IHC, IF, FC
Species Reactivity: Human, Mouse, Rat
-
Phospho-YAP1 (S127) Recombinant Monoclonal Antibody
Applications: ELISA, WB, IHC
Species Reactivity: Human
-
-
-
-
-